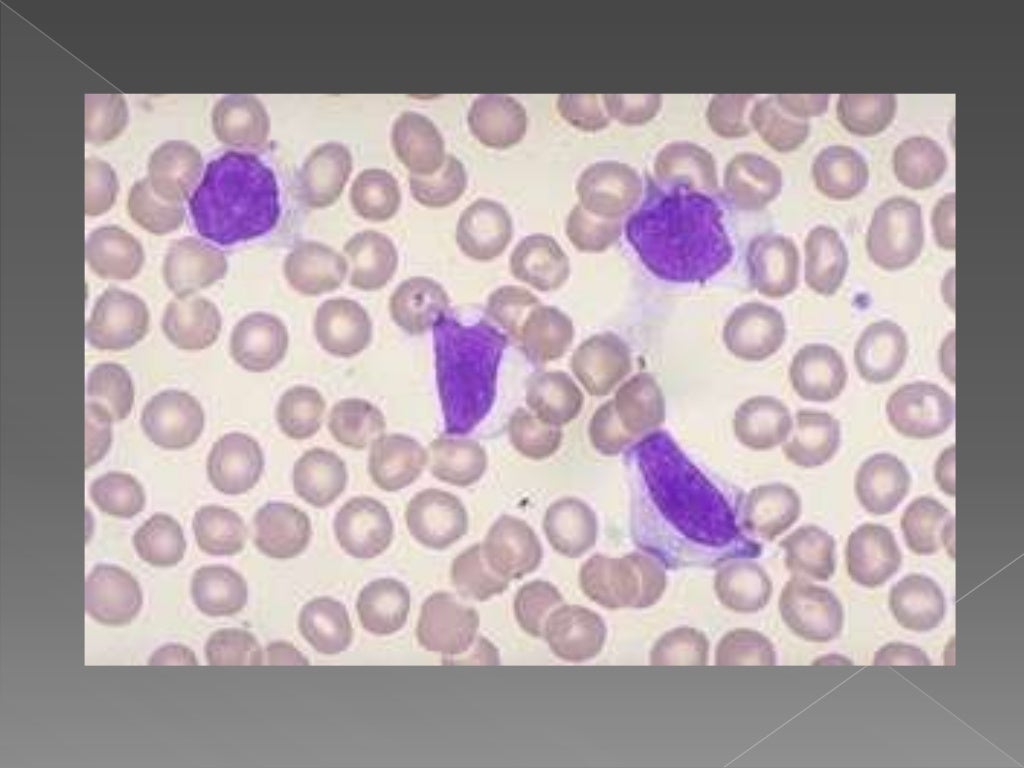

La mononucleosis infecciosa, que a veces se abrevia como “mono” en inglés, es una enfermedad contagiosa.
mononucleosis infecciosa Infectious mononucleosis is a clinical entity characterized by sore throat, cervical lymph node enlargement, fatigue and fever most often seen in adolescents and young adults. La mononucleosis infecciosa suele denominarse la enfermedad del beso. La mononucleosis infecciosa, que a veces se abrevia como “mono” en inglés, es una enfermedad contagiosa. Fatigue sore throat, perhaps misdiagnosed as strep throat, that doesn�t get better after treatment with. Infectious mononucleosis is characterized by swollen lymph glands, fever, sore throat, and chronic fatigue. La mononucleosis infecciosa, también conocida como enfermedad del beso, es una enfermedad contagiosa, causada por un virus de la familia del herpes. Infectious mononucleosis (im) is characterized by a triad of fever, tonsillar pharyngitis, and lymphadenopathy [ 1 ]. What is infectious mononucleosis and what causes it?

Mononucleosis infecciosa
Read This Also
- agustà n jimà nez
- 20 minutos
- 3 adivinanzas
- actividad formativa 4 movimientos acelerados y energà a
- acapulco kids
- acido clorhidrico
- a que equipo le va martinoli
- al toque deporte
- 21 junio 2020
- adivinanzas con doble sentido
Mononucleosis síntomas ⊛ ¡Prevención y Tratamiento 2020!

Source: sintomas.kim
Mononucleosis infecciosa

Source: es.slideshare.net
Mononucleosis Infecciosa en 2020 Faringitis, Antibioticos, Enfermedades

Source: www.pinterest.com
Pin on Patient Information Pages

Source: www.pinterest.com.mx
Mononucleosis infecciosa

Source: www.slideshare.net